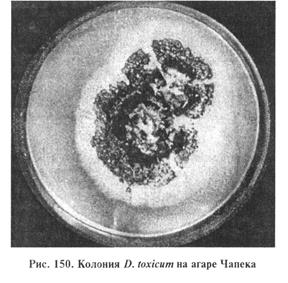

Главная страница Случайная страница
КАТЕГОРИИ:
АвтомобилиАстрономияБиологияГеографияДом и садДругие языкиДругоеИнформатикаИсторияКультураЛитератураЛогикаМатематикаМедицинаМеталлургияМеханикаОбразованиеОхрана трудаПедагогикаПолитикаПравоПсихологияРелигияРиторикаСоциологияСпортСтроительствоТехнологияТуризмФизикаФилософияФинансыХимияЧерчениеЭкологияЭкономикаЭлектроника
Лабораторная диагностика микотоксикозов, вызываемых грибами родов Aspergillus, Penicillium, Fusarium, Stachybotrys, Dendrodochium
|
|
Цель занятий. Ознакомить студентов с характеристикой мико-токсинов, вызывающих микотоксикозы, грибами-продуцентами этих токсинов и методами исследований для постановки диагноза на микотоксикозы.
Оборудование и материалы. Культуры грибов родов Aspergillus, PeniciUium, Fusarium, Stachybothrys и др. на агаре Чапека или других средах в чашках Петри (в больших пробирках), препаровальные иглы или микологические крючки, предметные и покровные стекла, микроскопы, таблицы и плакаты по данной теме.
МЕТОДИЧЕСКИЕ УКАЗАНИЯ
Микотоксикозы. Болезни животных и человека; характеризуются отравлением, которое возникает при поедании кормов (пищи), содержащих токсические продукты жизнедеятельности микроскопических грибов-плесеней — микотоксины (от греч. mykes — гриб и toxinum — яд). Известно около 250 видов различных микроскопических грибов, продуцирующих 100 токсических метаболитов. Природными субстратами грибов-продуцентов микотоксинов служат разнообразные сельскохозяйственные культуры. К микотоксинам чувствительны почти все виды домашних, диких животных, птицы и рыбы. Наименование микотоксикоза происходит от названия токсина или гриба-продуцента. При диагностике микотоксикоза наибольшее внимание уделяют обнаружению токсина, поскольку гриб-продуцент в ряде случаев к моменту исследования погибает и, кроме того, один и тот же микотоксин могут синтезировать различные виды грибов.
Лабораторная диагностика микотоксикозов основана на результатах токсико-биологических, органолептических, микологических и физико-химических исследований.
Материал для исследования. В лабораторию направляют пробы всех кормов, входивших в суточный рацион животного в течение одного месяца до проявления болезни, а также остатки кормов из кормушек, содержимое желудочно-кишечного тракта павших животных и др. Отбор средних проб корма проводят ветеринарные и зооинженерные специалисты с представителями предприятий. Отобранную среднюю пробу делят на две части, упаковывают в чистые сухие стеклянные банки объемом 2...3 л, герметически закрывают и пломбируют. Одну часть отправляют в лабораторию, другую хранят в хозяйстве в течение одного месяца в условиях, предотвращающих порчу или вторичное загрязнение. В документе указывают цель исследования, вид кормового средства, назначение, массу всей партии, место отбора пробы, основные клинические признаки у больных животных. Прилагают копию акта вскрытия трупов (при гибели животных), копию экспертиз ветеринарной лаборатории об исключении инфекционных болезней и отравлений животных химическими или растительными ядами (если такие исследования были проделаны лабораторией).
Органолептическое исследование. Определяют внешний вид, цвет, запах корма, выявляют признаки, отличающие дефектный корм от доброкачественного (изменение цвета; затхлый, плесневелый или гнилостный запах; наличие на поверхности корма мицелия гриба и др.). О санитарном качестве зерна можно косвенно судить по цвету и состоянию зерновых оболочек.
Токсикологическое исследование. Проводят на различных биологических моделях: кроликах, аквариумных рыбках гуппи породы Винер, белых мышах или сельскохозяйственных животных.
На кроликах ставят кожную пробу. К 50 г измельченного корма добавляют 150 мл диэтилового эфира (эфир для наркоза) или ацетона. Смесь встряхивают при комнатной температуре с помощью шуттель-аппарата 3 ч. Экстракт фильтруют и выпаривают до полного исчезновения запаха. Налет, оставшийся на стенках чашки, смывают небольшим количеством эфира и используют для биопробы, которую ставят на кроликах массой 2...2, 5 кг. Предварительно у кролика в области бедра, лопатки или бока выстригают участок кожи 6 см2. Пигментированная или с признаками шелушения кожа непригодна для исследования.
На одном кролике можно ставить не более четырех проб. На выстриженный участок кожи кролика наносят стеклянной лопаткой половину экстракта и легко втирают его. При восковидной консистенции экстракта его предварительно подогревают. Часть участка оставляют свободной от экстракта как контрольную. Через 24 ч наносят оставшийся экстракт. Чтобы предупредить его слизывание, кролику надевают воротник (не менее чем на три дня). Учет проводят на следующий день после повторного нанесения экстракта и продолжают вести наблюдение в течение 3...5 дней в зависимости от реакции, после чего дают окончательную оценку: а) корм нетоксичный — отсутствуют воспалительная реакция и изменения на коже; б) корм слаботоксичный — шелушение кожи, отечность, болезненность, незначительное утолщение кожи с образованием отдельных корочек; в) корм токсичный — резкая гиперемия, отек, утолщение кожи, болезненность, появление язвы и струпа.
В качестве дополнительного теста определяют токсичность кормов на аквариумных рыбках. Методика основана на извлечении микотоксинов из фуражного зерна, продуктов его переработки и комбикормов, экстракции хлороформом и исследовании на рыбках гуппи. В раствор экстракта помещают 5 рыбок независимо от пола и возраста. Ведут наблюдение в течение 24...30 ч. Оценка степени токсичности корма: а) нетоксичный — при гибели не более одной рыбки в течение 24 ч; б) слаботоксичный — при гибели 2...4 рыбок; в) токсичный — при гибели всех 5 гуппи за тот же отрезок времени.
Методика определения токсичности корма на белых мышах основана на извлечении токсических веществ из жмыхов, кормовых дрожжей ацетоном и введении концентрированного экстракта однократно в желудок мышам массой 20...25 г. Животных наблюдают в течение 3 сут, не ограничивая их в корме и питье. Оценка результатов корма: а) нетоксичный — мыши живы, на вскрытии у убитых мышей патологоанатомических изменений нет; б) слаботоксичный — мыши живы, при вскрытии у убитых обнаруживают геморрагическое воспаление желудочно-кишечного тракта, чаще очаговое; в) токсичный — гибнут все мыши (или одна), на вскрытии павших или убитых устанавливают геморрагическое воспаление желудочно-кишечного тракта, часто дегенерацию тканей печени, почек или кровоизлияние в паренхиматозных органах. Если токсичность корма не выявлена всеми перечисленными методами, подозрительные корма скармливают лабораторным животным (цыплятам, утятам, голубям, белым мышам, морским свинкам, кроликам) или животным тех видов, которые болели в хозяйстве.
Микологический анализ. Включает в себя выделение из кормов и идентификацию грибов-продуцентов микотоксинов. С этой целью из кормов делают посевы в чашки Петри с агаром Чапека, сусло-агаром или в жидкую среду Билай. Грубые корма высевают во влажные камеры со средой Ван—Итерсона. Перед посевом агар расплавляют в водяной бане, после охлаждения до 45...50 º С в него для подавления роста сопутствующей микрофлоры добавляют антибиотики (пенициллина 5*104 ЕД/л и стрептомицина 105 ЕД/л среды). Для приготовления влажной камеры со средой Ван—Итерсона на дно чашки Петри кладут слой ваты с кружком фильтровальной бумаги по диаметру чашки и стерилизуют в сушильном шкафу. Перед посевом на фильтровальную бумагу наливают среду Ван—Итерсона до увлажнения бумаги, не создавая избытка влаги (около 5 мл).
Для выделения грибов из зерен последние раскладывают по поверхности фильтровальной бумаги по 10 штук, чтобы они не соприкасались одно с другим. Посевы культивируют при 22...25 °С 3...10 дней до образования характерного спороношения, после чего проводят макро- и микроскопическое исследование культур грибов с целью идентификации.
При макроскопическом исследовании учитывают различные признаки выросших колоний: цвет, форму, консистенцию, характер роста, образование склероциев, выделение пигмента, степень развития воздушного мицелия. Затем готовят препараты «раздавленная капля». Микологическим крючком или препаровальной иглой берут частицы мицелия (желательно со спороношением из молодых культур с периферии, от старых — из центра колоний) и вносят их в фиксирующую жидкость. Другой иглой материал расправляют на предметном стекле и покрывают покровным стеклом, слегка прижимая его. Микроскопируют с помощью малого объектива (х8, х40) или в иммерсионной системе при слегка спущенном конденсоре. Токсичность культур определяют методом кожной пробы на кроликах или другим способом.
Физико-химический анализ. Его цель — качественное и количественное определение микотоксинов в кормах и других материалах с помощью различных методов — люминесцентного анализа, хроматографии и т.д..
При оценке результатов анализов необходимо учитывать данные всех исследований, а в случае постановки диагноза — клинические признаки и характер патологоанатомических изменений.
Афлатоксикозы. Заболевания, возникающие при поедании животными кормов, содержащих афлатоксины. Все афлатоксины (В1, В2, С1, С2 и их производные M15, М2 и др.) отнесены к фурокумаринам. Афлатоксин М1 — продукт метаболизма афлатоксина В1 выделяющийся с молоком. В естественных условиях афлатоксины встречаются в растительных продуктах, кроме того, некоторые токсигенные штаммы грибов (Aspergillus flavus и A. parasiticus и др.) вырабатывают их при определенной температуре и влажности.
Природные субстраты грибов-продуцентов: арахис, кукуруза и другие различные зерновые и бобовые культуры, семена хлопчатника и др. (рис. 136).

Афлатоксины оказывают гепатотоксическое и гепатоканцерогенное, мутагенное, тератогенное и иммунодепрессивное действие (рис. 137).

Наиболее чувствительны к афлатоксинам поросята в возрасте до 3 мес, супоросные свиноматки, телята, откормочные свиньи, взрослый крупный рогатый скот и овцы, лошади, птицы (утки, индейки, гуси, фазаны, куры). Дефицит в кормах витаминов, белка или нарушение у животных обмена веществ повышают чувствительность животных к афлатоксинам.
Лабораторная диагностика афлатоксикозов включает в себя выделение афлатоксина и определение его количества методом тонкослойной хроматографии согласно действующей инструкции. Подтверждением служит обнаружение афлатоксина в органах и тканях животного. Если в пробах не выделены афлатоксины, диагноз ставят по результатам выделения гриба-продуцента из фекалий или содержимого желудочно-кишечного тракта, остатков корма или пыли, взятых из силоса или бункера, где хранился корм, и воспроизведения в эксперименте культурой этого гриба заболевания (биопроба), аналогичного по всем признакам, которые наблюдали в хозяйстве.
Материал для исследования. В лабораторию отправляют корма, молоко, фекалии; от павших животных — печень, почки, мышечную ткань.
Выделение и идентификация грибов рода Aspergillus, а также культуральные и морфологические свойства описаны в теме 37.
Охратоксикозы. Заболевания, возникающие при поедании животными кормов, содержащих охратоксины — производные гидроизокумарина. Из известных охратоксинов — А, В, С и D — наиболее токсичен охратоксин А, который относят к группе кислых микотоксинов, экстрагирующихся из корма при кислом рН.
Типичные продуценты охратоксинов: грибы Aspergillus ochraceum, от которых произошло название микотоксина (именно из них токсин был впервые выделен), и Penicillium viridicatum. Охратоксины могут продуцировать и другие грибы рода Aspergillus и Penicillium. Токсигенные штаммы A. ochraceus в большинстве своем, кроме охратоксинов, образуют пенициллиновую кислоту, а штаммы P. viridicatum — цитрины. Поэтому на практике корма могут быть заражены сразу несколькими токсинами. Однако основным токсическим агентом в этих случаях является охратоксин А.
Природные субстраты A. ochraceus и P. viridicatum: ячмень, кукуруза, овес, пшеница, горох, рис, гречиха, соевые бобы, арахис, фасоль, земляные орехи, кофе и др.
Охратоксины оказывают на организм животных нефротоксическое, тератогенное и канцерогенное действие. Охратоксикозам подвержены свиньи, птицы, крупный рогатый скот, лошади. Очень чувствительны к охратоксинам собаки.
Лабораторная диагностика охратоксикозов направлена на обнаружение токсина или грибов-продуцентов и основана на результатах токсико-микологического и физико-химического анализа кормов и патологического материала. Методы определения микотоксина и идентификации грибов-продуцентов описаны в данной теме. Выделение и идентификация грибов рода Aspergillus и Penicillium описаны в теме 37.
Пенициллотоксикозы. Заболевания, возникающие при поедании животными кормов, зараженных микотоксином — пеницилловой кислотой. Последнюю длительное время применяли как антибиотик, но из-за высокой токсичности в лечебной практике больше не используют.
Продуценты пеницилловой кислоты: различные виды грибов, преимущественно рода Penicillium — P. ruberulum, P. cyclopium, P. viridicatum и др. и некоторые варианты грибов родов Aspergillus, A. ochraceus, A. sulphureus.
Природные субстраты этих грибов: кукуруза, бобовые корма, табак.
По сравнению с фузарио- и аспергиллотоксикозами пенициллотоксикозы изучены недостаточно. Наиболее чувствительны к пеницилловой кислоте свиньи. Под влиянием этого токсина у животных происходит расширение кровеносных сосудов, глубокие дистрофические изменения в проксимальных канальцах почек. Пеницилловая кислота оказывает цитотоксическое, кардио-токсическое и канцерогенное действие на организм животных. В развитии смешанного микотоксикоза свиней, кроме различных токсинов, продуцируемых грибами рода Penicillium, принимает участие пеницилловая кислота.
Лабораторная диагностика пенициллотоксикозов основана на результатах токсико-микологического анализа, проводимого для обнаружения токсина или гриба-продуцента.
Рубратоксикозы. Группа болезней, развивающихся при скармливании животным кормов, загрязненных рубратоксинами А, В, С. Наиболее распространен рубратоксин В.
Грибы-продуценты рубратоксина — Penicillium rubrum и P. purpurogenes. Последний вырабатывает в больших количествах рубратоксин В. Указанные грибы нередко выделяют из кормов вместе с токсигенными A.flavus, что говорит о возможности их синергического действия при совместном развитии на кормах.
Природные субстраты P. rubrum и P. purpurogenes: различные зерновые, бобовые, арахис, корма, семена подсолнечника и др.
Из сельскохозяйственных животных наиболее чувствительны к рубратоксину свиньи, особенно поросята. Наиболее остро и с высоким летальным исходом болезнь протекает у новорожденных поросят (токсин выделяется с молоком). Рубратоксины А и В оказывают гепатотоксическое, мутагенное и тератогенное действие на животных.
Лабораторная диагностика рубратоксикозов включает в себя выделение и идентификацию грибов рода Penicillium (см. тему 37).
Для воспроизведения заболевания в эксперименте ставят биопробу на двух свиноматках с новорожденными поросятами из благополучного по инфекционным болезням хозяйства. Свиноматкам скармливают корм, загрязненный выделенной культурой гриба.
При положительном результате биопробы у свиноматок появляются признаки отравления: диарея, угнетение, частичный отказ от корма. Поросята после первого сосания свиноматки заболевают и погибают на 4...5-й день. Клинические признаки, патологоанатомические изменения у подопытных животных аналогичны наблюдаемым в хозяйствах.
Фузариотоксикозы. Заболевания, развивающиеся при скармливании животным кормов, загрязненных микотокси-нами, продуцируемыми грибами только рода Fusarium, могут быть вызваны отдельными микотоксинами или их комбинацией. Фузариотоксикозы различают по видам микотоксинов.
Ф-2 токсикоз (микотоксический токсикоз, вульвовагинит неполовозрелых свинок). Болезнь вызывает зеараленон (токсин Ф-2, ферментативно-эстрогенное вещество (ФЭВ) и его производные: α и β -зеараленоны. Микотоксин оказывает на организм животного эстрогенное (вызывающее охоту) и тератогенное воздействие.
Продуценты микотоксина зеараленона — грибы F. graminearum, F. moniliforme и др. — типичные почвенные микроорганизмы, способные развиваться на влажном корме при его хранении. Грибы хорошо растут на зерне пшеницы, кукурузы, сорго, хуже на зерне ячменя и овса, в сене. К зеараленонтоксикозам восприимчивы свиньи, крупный рогатый скот (болезнь характеризуется массовыми вульвовагинитами, отечностью молочной железы, у хряков отеком препуция). Наиболее чувствительны свиньи и хряки в возрасте 2...5 мес. α -Зеараленон в 3...4 раза, а β -зеараленон в 1, 2 раза активнее по эстрогенному действию, чем зеараленон. В основном они влияют на матку, яичники, тестикулы и молочные железы. Из организма ассимилированный зеараленон и его токсические метаболиты выделяются с желчью, фекалиями и мочой, а у лактирующих животных и с молоком. На птиц зеараленон действует слабее.
Лабораторная диагностика Ф-2 токсикоза (зеараленонтоксикоза) основана на обнаружении токсических доз микотоксина в корме и его токсических метаболитов α и β в органах и тканях животных; при подостром течении болезни — в фекалиях. Микотоксикологическое исследование (кукурузы, кормов) проводят с целью обнаружения гриба-продуцента.
При микотоксикологическом исследовании необходимо исключить отравления, вызванные люцерной, клевером и другими бобовыми, содержащими эстрогенные вещества. При органолептическом исследовании выявляют пораженные грибами зерновые корма — легковесные зерна с матово-серой оболочкой; иногда на оболочке заметны пятна или коростинки красного и розово-оранжевого цвета, представляющие собой грибницы или спороношение гриба. Такую окраску можно обнаружить и в самом зерне при его надломе.
Материал для исследования. В лабораторию отправляют корм, пораженные органы и ткани животных.
Микроскопия препаратов из исходного материала. Соскобы с пораженных зерен, отобранных при органолептическом исследовании, помещают на предметное стекло в каплю 50%-го водного раствора глицерина, накрывают покровным стеклом и микроскопируют. В поле зрения обнаруживают характерный для грибов рода Fusarium септированный мицелий, макроконидии из нескольких крупных удлиненных клеток веретенообразной или серповидной формы или микроконидии (более мелкие), чаще одноклеточные на простых или разветвленных конидиеносцах. Иногда находят хламидоспоры, склероции.
Выделение и идентификация грибов рода Fusarium. Грибы хорошо растут на агаре Чапека, сусло-агаре и среде Билай с рН 4, 5...5, 6 при температуре 18...24°С.
На твердых питательных средах F. graminearum образует колонии с хлопьевидным пушистым белым, бело-розовым или кроваво-красным мицелием.
При изучении морфологии выросшей культуры грибов обнаруживают на воздушном мицелии спородохии (сплетения конидиеносцев в виде подушечек на поверхности гифов), состоящие из макроконидий различной формы (веретеновидные, серповидные, эллиптически изогнутые, конические). Встречаются розовые или темно-красные склероции. Иногда обнаруживают промежуточные хламидоспоры.
С помощью токсикобиологического анализа выявляют дермонекротическое действие микотоксинов, находящихся в корме. Ф-2 токсин не оказывает дермо-некротическое действие, не вызывает летального исхода. Методы микотоксикобиологических исследований описаны ранее.
Т-2 токсикоз. Заболевание животных, возникающее при поедании корма, загрязненного трихотеценовым микотоксином Т-2. Это наиболее изученный из типичных фузариотоксинов, продуцент которого — гриб Fusarium sporotrichioides (син. F. tricinctum).
Биологическое действие токсина Т-2 многостороннее: он поражает сердечно-сосудистую и нервную системы, угнетает развитие лимфоидных органов у растущих животных, снижает количество лейкоцитов в крови, ухудшает процесс выработки антител после активной иммунизации на ранней стадии развития иммунной реакции у животных, нарушает функции Т- и В-лимфоцитов, ингибирует биосинтез белка. Токсин Т-2 более опасен, чем другие известные микотоксины, продуцируемые грибами родов Aspergillus и Penicillium. Наиболее чувствительны к данному микотоксину крупный рогатый скот, свиньи, птицы, которым скармливают токсический корм (зерно). Чувствителен к отравлению и человек при поедании так называемого «пьяного хлеба», выпеченного из зерна, пораженного токсигенным грибом.
Природные субстраты гриба F. sporotrichioides: кукуруза, силос, сено, пшеница и др.
Для постановки диагноза достаточно обнаружить определенное количество токсина в кормах согласно методике качественного определения микотоксина Т-2 в зернофураже. Для микотоксикологического исследования корма необходимо предварительно исключить инфекционную природу болезни (отечную болезнь у свиней и др.), а также отравления ядовитыми растениями, минеральными и органическими ядами.
Токсикологическое исследование корма. Обязательно проводят биопробой на коже кролика. Методика описана выше. Токсин Т-2 оказывает резко выраженное дермонекротическое действие (рис. 138).
 Рис. 138. Некроз кожи у кролика с образованием толстого струпа на месте нанесения эфирной вытяжки из культуры F. sporotrichioides, выращенной на овсе
Рис. 138. Некроз кожи у кролика с образованием толстого струпа на месте нанесения эфирной вытяжки из культуры F. sporotrichioides, выращенной на овсе
Выделение и идентификация гриба F. sporotrichioides. Посевы культивируют из исследуемого материала, как при микотоксикозе Ф-2, после чего изучают культуральные и морфологические признаки выросших культур.
F. sporotrichioides образуют колонии с хорошо развитым воздушным мицелием белого, розового или желтоватого цвета (рис. 139).

В препаратах из колоний обнаруживают микроконидии, чаще одноклеточные, реже с одной или тремя перегородками, грушевидной или лимоновидной, шаровидно-яйцевидной или веретенно-шаровидной формы (рис. 140). Встречаются также макроконидии веретенно-серповидной формы (рис. 141). Может быть обильное количество хламидоспор.


Стахиботриотоксикоз. Остро или подостро протекающий микотоксикоз, возникающий при поедании животными кормов и подстилки, загрязненных грибами Stachybotrys altemans (син. S. atra) или токсическими метаболитами этого гриба. Болезнь проявляется в виде поражений кожи, общего токсикоза, абортов, нарушений иммунной и нервной систем, изменений в кроветворных органах, тяжелых расстройств желудочно-кишечного тракта. Отмечают слабое прикрепление волос, иногда многочисленные кровоизлияния на бесшерстных местах. Частные признаки болезни: конъюнктивит, гиперемия слизистой оболочки ротовой полости и носа, саливация и серозные, позднее серозно-геморрагические выделения из носа, некротические очаги на слизистой оболочке ротовой полости. Чаще обнаруживают некротические язвы на деснах вокруг зубов и на языке (рис. 142).

К стахиботриотоксикозу чувствительны лошади, крупный рогатый скот, овцы, птицы, свиньи.
Возбудитель стахиботриотоксикоза относят к высшим несовершенным грибам (класс Deuteromycetes) рода Stachybotrys (активные разрушители целлюлозы). Stachybotrys alternans образует сатратоксины A, D, F и другие, которые относят к группе трихотеценов. Трихотецены (известно около 60 токсинов) оказывают на животных нейротоксическое, геморрагическое, лейкопеническое, иммунодепрессивное, дермотоксическое, тератогенное действие. Токсин гриба Stachybotrys alternans образуется постепенно в стеригмах, конидиях и конидиеносцах и накапливается в субстрате. Токсин устойчив к нагреванию, даже автоклавированию, но инактивируется под действием щелочей и хлора. С прекращением роста гриба заканчиваются образование и накопление микотоксина (10...25 дней).
Природные субстраты гриба: солома (ячменная, ржаная, пшеничная, овсяная), сено (чаще злаковое), зерно (ячмень, овес), кукуруза, рис, горох, хлопок.
Лабораторная диагностика стахиботриотоксикоза основана на органолептическом, токсико-биологическом и микологическом исследовании корма.
Органолептическое исследование. При осмотре кормов обращают внимание на наличие темного или черного налета на стеблях соломы (сена). В дифференциальном диагнозе исключают сап.
Микроскопия препаратов из исходного материала. Обращают внимание на наличие вегетативных и репродуктивных структур, характерных для гриба. Соломинки, пораженные грибом S. alternans, отбирают с помощью лупы по черному порошистому налету, особенно в узлах соломинок. Налет соскабливают, помещают на предметное стекло в каплю 50%-го водного раствора глицерина, накрывают покровным стеклом и микроскопируют. В поле зрения обнаруживают темноокрашенные конидиеносцы и опавшие споры гриба (рис. 143).

Рис. 143. Конидиеносец (а) и конидии (6) Stachybotrys alternans
Выделение и идентификация гриба S. alternans. Аэроб, температурный оптимум 24...26°С, рН 6, 8...7, 0, влажность 45...50%. При влажности 20 % не растет. Гриб хорошо развивается на естественных субстратах и на искусственных питательных средах: Ван—Итерсона, на агаре Чапека или сусло-агаре. В чашках Петри на фильтровальной бумаге, смоченной средой Ван—Итерсона, S. alternans образует колонии от темно-серого до черного цвета (рис. 144).

На агаре Чапека гриб образует колонии с двумя зонами (рис. 145). Центральная зона складчатая, черного цвета, по периферии отмечают белую прозрачную каемку. Цвет питательной среды вокруг колоний бурый, нередко с темно-вишневым оттенком. На сусло-агаре S. alternans образует черные колонии с бороздками, радиально расходящимися от центра.

Цвет мицелия в молодой культуре бледно-оливковый, с возрастом становится оливково-бурым. Конидиеносцы также изменяются в зависимости от возраста и могут быть простыми и разветвленными, с редкими перегородками. На верхушке конидиеносца можно наблюдать сросшиеся у основания яйцевидные стеригмы, называемые мутовками. На вершине стеригм образуются одноклеточные округлые конидии. В молодой культуре они гладкие, бледно-оливкового цвета. Зрелые конидии отличаются шиповидно-бородавчатой формой, непрозрачностью и черным цветом. Каждая стеригма образует по 3...7 конидий. Они склеиваются рлизью и формируют головку на пучке стеригм (рис. 146).

Дендродохиотоксикоз. Тяжелопротекающий микотоксикоз, часто с молниеносной гибелью. Характеризуется расстройством центральной нервной, сердечно-сосудистой и пищеварительной систем, кровоизлияниями во внутренних органах, язвенно-некротическими процессами на пятачке (у свиней), коже губ и слизистой оболочке ротовой полости, дегенеративными изменениями в паренхиматозных органах. В отличие от стахиботриотоксикоза при дендродохиотоксикозе отсутствуют кровоизлияния в паренхиматозных органах и изъязвления желудка.
Возбудитель — гриб Dendrodochium toxicum (рис. 147). Из гриба выделен микотоксин дендродохитоксин (дендродохин), который относят к трихотеценам. Из всех известных трихотеценовых микотоксинов дендродохин наиболее токсичен. Токсин образуется при 25 °С в субстрате, на котором растет гриб, в его мицелии и конидиях. Однократная доза 350...450 г пораженной соломы вызывает гибель лошадей в течение нескольких часов после приема корма. Дендродохин устойчив к высокой температуре, выдерживает нагревание в течение 1 ч при 125°С.

Лабораторная диагностика дендродохиотоксикоза основана на результатах главным образом токсико-микологического анализа кормов, из которых выделяют гриб D. toxicum.
Материал для исследования. Грубые корма, в основном солома, мякина, сырой хлопок и другие растительные остатки, а также овес, суданская трава, конопля, горох, которые служат природными субстратами для гриба D. toxicum.
Органолептическое исследование. Проводят в целях профилактики болезни за месяц до скармливания кормов животным.
На соломе чаще обнаруживают мицелий гриба и очень редко конидию. Часто у корма нормальный внешний вид, так как гриб разрастается в основном внутри субстрата.
Микроскопическое исследование. Проводят после посева исследуемого материала на растительные субстраты и питательные среды (рис. 148).

Токсико-биологическое исследование. Заключается в извлечении из корма токсических веществ и определении их дер-монекротического действия на кроликах. В качестве дополнительных исследований используют метод определения токсичности кормов на аквариумных рыбках и белых мышах, морских свинках и крысах. Методики описаны выше.
Выделение и идентификация гриба D. toxicum. Аэроб, хорошо растет на естественных средах: сене, ячмене и на обычных лабораторных средах: агаре Сабуро, сусло-агаре, среде Чапека и др. Температурный оптимум 20...25°С (диапазон 7...35°С). При более низкой температуре гриб образует только мицелий. Оптимальная кислотность питательных сред для роста и развития гриба рН 6, 0...7, 0. На растительных субстратах на 3...4-й день после посева появляются небольшие рыхлые мицелиальные подушечки, а затем на 10...12-й день — спородохии (рис. 149). Спородохии — тесный слой коротких, часто разветвленных конидиеносцев на поверхности выпуклого сплетения гиф и стромы в виде подушечек. Мицелий бесцветный, гифы септированные.
Рис. 149. Зерна овса, зараженного грибом D. toxicum (на зерновой оболочке темные спородохии гриба окружены белой каймой мицелия  )
)
На агаре Сабуро обнаруживают шаровидные, реже грушевидные, интеркалярные и терминальные хламидоспоры. На жидких средах гриб растет на поверхности субстрата в виде пленчатого, вначале пушистого мицелия. На 5...7-й день развиваются спородохии. На агаре Чапека (рис. 150) при комнатной температуре гриб образует пушистый воздушный мицелий белого цвета, спородохии развиваются медленно. При температуре 22...25 °С образуется белый стелющийся мицелий, колонии круглые, спородохии появляются на 4...5-й день. Спородохии — поверхностные, округлые или неправильной формы, 1, 2 мм в диаметре. По периферии окаймлены белым плоским мицелиальным ободком, в центре — оливково-черный слой конидий. С возрастом отдельные спородохии сливаются и образуют сплошной оливково-черный слой.
ЗАДАНИЯ ДЛЯ САМОСТОЯТЕЛЬНОЙ РАБОТЫ
1. Изучить культурально-морфологические свойства грибов родов Aspergillus, Penicillium, Fusarium, Stachybotrys.
2. Провести органолептический анализ пораженных плесневыми грибами кормов (комбикорма, сено).
3. Ознакомиться с результатами дермонекротической пробы на кролике.
4. Составить схему лабораторного исследования на микоток-сикозы.
Контрольные вопросы
1. В чем основные отличия микозов от микотоксикозов?
2. Каковы морфологические и культуральные свойства возбудителей микотоксикозов?
3. Какой материал отправляют в лабораторию и в чем состоит его исследование на выявление микотоксинов?
4. Как ставят биопробу при диагностике микозов и микотоксикозов?
5. На каких питательных средах культивируют возбудители микозов и микотоксикозов?